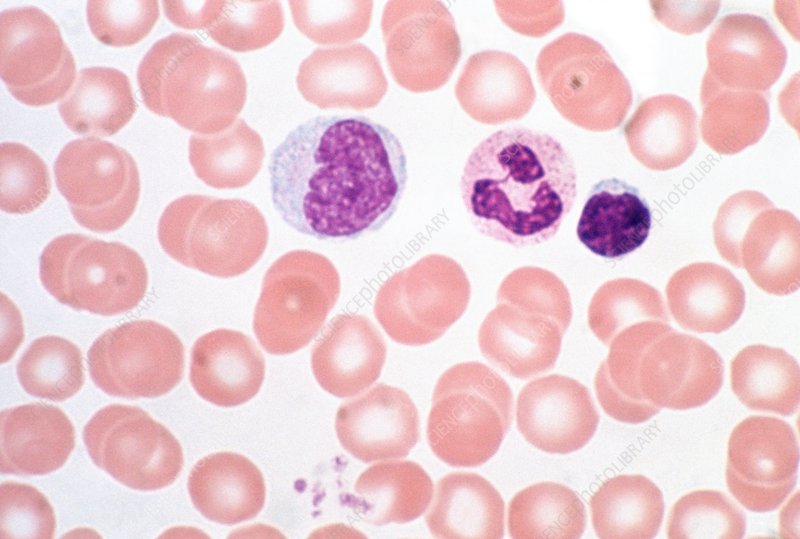
<p>vascular tissue (blood)</p>

1/54
Name | Mastery | Learn | Test | Matching | Spaced | Call with Kai |
|---|
No analytics yet
Send a link to your students to track their progress
EPITHELIA
lining, covering, & glandular tissue of the body
glandular — forms glands
lining & covering — covers all free body surfaces; various versatile cells
functions: protection, absorption, filtration, secretion

apical surface
free “outer” surface of an epithelium

basement membrane
structureless material that supports epithelial cells; secreted by epithelial & nearby connective tissue cells
simple epithelium
epithelium made up of one layer of cells
stratified epithelium
epithelium made up of more than one layer of cells

simple squamous epithelium
functions: diffusion, filtration, secretion (serous membranes)
locations: air sacs in lungs, capillary walls, serous membranes (line ventral cavity & cover organs)

simple cuboidal epithelium
functions: secretion, absorption
locations: glands, ducts, walls of kidneys, surface of ovaries

simple columnar epithelium
functions: secretion, absorption; ciliated cells propel mucus et al
locations: digestive tract (stomach to anus), mucus membranes

pseudostratified columnar epithelium
like columnar except cells are different lengths & shapes; nuclei appear to be all over the place
functions: absorption, secretion; ciliated cells propel mucus et al
locations: respiratory tract (ciliated)

goblet cell
epithelial cells that secrete mucus and look like goblets
often found in conjunction with columnar & pseudostratified columnar cells

stratified squamous epithelium
most common stratified epithelium
usually consists of several cell types: squamous at free edges, cuboidal/columnar close to basement membrane
function: protection!!
locations: esophagus, mouth, superficial portion of skin
stratified cuboidal & columnar epithelia
cuboidal: at least surface layer of cells are cuboidal
columnar: surface layer of cells are columnar, basal cells vary in size & shape
quite rare in the body; if present, largely found in large ducts (protection)

transitional epithelium
highly modified stratified squamous
basal cells are cuboidal/columnar; apical cells vary but are all dome-like
cells characterized by ability to slide past one another & change shape
functions: protection, allowing for stretching
locations: urinary bladder, ureters, urethra (all urinary system)

glandular epithelium
function: secretion
locations: glands
endocrine vs. exocrine glands
ENDOCRINE
no connection to the surface; no ducts
secretions diffuse directly into the bloodstream
ex.: thyroid, adrenal, pituitary
EXOCRINE
ducts connect them to the surface
secretions move through ducts
ex.: sweat, oil, & salivary glands
SECRETION
process by which substances are produced & discharged from cells, glands, or organs
secretion pathway in gland cell: endoplasmic reticulum —> golgi complex —> secretory vesicles —> secretion

merocrine secretion
secretory process in which secretions are released from secretory vesicles at the surface of the gland cell by exocytosis
(merocrine = maintain)

apocrine secretion
secretory process in which the apical surface (part of cytoplasm & membrane) of the gland and the associated secretory vesicles are shed; the cell then grows and repairs itself before releasing additional secretions
(apocrine = apical)

holocrine secretion
secretory process in which superficial cells in glandular epithelia form secretions, increase in size, and then burst; the basal cells undergo constant division to replace lost cells
(holocrine = whole)
CONNECTIVE TISSUE
connects body parts
distinguishing factors: variations in blood supply, extracellular matrix
functions: protecting, supporting, binding
locations: everywhere in the body; most widely-distributed tissue type
extracellular matrix
distinguishes different connective tissue types from each other
produced by connective tissue cells & secreted to exterior
made up of two main components: structureless ground substance & fibers
ground substance: largely made of water, proteins, & polysaccharide molecules
fibers: type & amount vary based on tissue type; incl. collagen (strength; secreted by chondrocytes), elastic, reticular (fine collagen fibers; structure)

osseous (compact bone) tissue
composed of osteoblasts and osteocytes (bone cells), which live in little cavities called lacunae
osteoblasts at the center, surrounded by lacunae containing osteocytes
matrix: very hard, contains lots of calcium salts & collagen fibers
function: protect & support other body organs

hyaline cartilage
most widespread type of cartilage
less hard & more flexible than bone
limited blood supply
matrix: slippery, rubbery, glassy, “smooth”
locations: supporting structures of larynx, connecting ribs to sternum, medium- and low-stress joints (fingers, elbows, etc.)

fibrocartilage
stronger and stiffer than hyaline cartilage; highly-compressible
limited blood supply
matrix: lots of collagen, looks kind of fibrous
locations: spinal discs, between high-stress joints (hips, knees, etc.)

elastic cartilage
elastic; pretty self-explanatory
limited blood supply
matrix: chondrocytes, proteins, looks sketchy/fiber-y
locations: external ear, tip of nose

dense regular fibrous connective tissue
ideal for areas that need uniform structure
matrix: very dense, many collagen fibers that run more or less parallel to one another, fibroblasts crowded between collagen fibers
locations: tendons, ligaments

cancellous (spongy bone) tissue
matrix: open spaces, a lot less dense than compact bone
locations: marrow (inside bones)

dense irregular fibrous connective tissue
matrix: like dense regular but the fibers inside of it aren’t parallel, they’re running in all different directions
locations: dermis, eyeball’s protective coating

areolar (loose) connective tissue
most common connective tissue in the body
cushions & protects body organs; also holds them in place
loose, fluid matrix acts as a reservoir for water & salts; nearly all body cells get their nutrients from & release waste into the matrix
when a region of the body is inflamed, surrounding areolar tissue soaks up excess fluid & causes swelling
matrix: soft, pliable, cobweb-like; long elastic fibers running throughout; collagen fibers & fibroblasts throughout
micrographs look kind of like a big jumble of stuff
locations: beneath epithelium of skin & mucus membranes, between muscles, around blood vessels & joints, etc.

adipose (fat) tissue
protects, cushions, insulates, acts as energy store
matrix: ground substance surrounding large fat-containing vacuoles; looks like it has big empty rings in it
locations: subcutaneous tissue, around some organs, fat deposits, behind the eyes

reticular (lymphatic) tissue
makes up stroma (internal framework) in lymphoid organs
matrix: large, thick reticular fibers throughout which are surrounded by reticular cells & white blood cells
locations: lymph nodes, spleen, bone marrow
vascular tissue (blood)
fluid connective tissue
“connects” different parts of the body by travelling all over and carrying around waste, nutrients, hormones, water, etc.
matrix: plasma (clear-ish fluid) surrounding red blood cells (little circles w/ light centers), white blood cells, and fibers (present themselves during clotting)
locations: inside blood vessels
MUSCLE TISSUE
highly specialized tissue whose primary function is to contract in order to produce movement

skeletal muscle
formation/organization process: myoblasts —> fuse to form one cylindrical, multinucleated muscle fiber (myofibril) —> come together to form fascicles (surrounded by perimysium; like bridge cables; large “fiber” chunks you actually see) —> come together to form an even larger muscle (surrounded by epimysium; whole thick proper muscles)
very obvious striations
fibers are arranged parallel to one another
99% of movement is voluntary; only muscle type to be able to do so
found all throughout the body, allows for movement, gives the body shape

cardiac muscle
found only in the heart
contracts —> changes size of space inside heart —> pumps blood out/lets blood flow in
short, branching cells with one nucleus each; cells run in many different directions
space between them is bridged by intercalated discs
lightly striated
99% of movement is involuntary

visceral (smooth) muscle
no visible striations; i mean, it looks smooth
spindle-shaped cells with lots of space in between
found in walls of hollow organs (stomach, intestines, uterus, blood vessels)
contracts (slowly) —> changes size of space inside organs —> propels fluid through organs
ex.: peristalsis keeps food moving through digestive system
99% of movement is involuntary
NERVOUS TISSUE
highly-specialized tissue that is made up of neuroglia and neurons
neuroglia
supporting cells in the nervous system; insulate, support, and protect neurons

neurons
highly-specialized cells that receive and conduct electrical impulses in order to communicate quickly
can vary from a few mm to over 3ft in length
locations: brain, spinal cord, scattered throughout the body (nerves)

dendrites
LIGHT YELLOW
conduct impulses towards the soma (AFFERENT)
will only send an impulse if the stimulus passes the threshold; it’s a fire/no fire process, no half-impulses
help increase the surface area of the neuron so that stimuli can be received with better accuracy and in higher volume (if there are enough dendrites)

soma
LIGHT GREEN
cell body of the neuron
stimuli being received by dendrites kind of collect within the soma; once there’s enough to meet the threshold, the impulse generates

axon
RED
conduct impulses away from the soma (EFFERENT)
length of axon determines speed at which impulses are sent
longer axons must transport impulses over greater distances —> it takes longer for them to send impulses —> they tend to get more myelin
wider/thicker axons conduct faster than thinner axons
made up of axoplasm inside axolemma (outer membrane)

myelin sheath
ORANGE
“insulation” covering the axon that helps limit resistance, which speeds up transmission of impulses
works kind of like covering on wires; prevents impulses from “jumping off” axon, protects from outside interference, etc.
made up of myelin lipids

nodes of Ranvier
BLUE
small gaps in the myelin sheath
facilitates saltatory conduction — impulses “jump” between nodes of Ranvier bc impulses can only be conducted (ion exchange) directly on non-myelinated axon
speeds up transmission of impulses bc they don’t have to travel the entire length of the axon

axon terminals
DARK YELLOW
discharge impulses from the neuron once they’ve travelled through the axon (EFFERENT)
form synaptic contacts with other neurons (continuing chain of communication) OR effector cells (carry out actions)

telodendria
PINK
little branching ends of the axon, lead into axon terminals

neuroglial (Schwann) cell
DARK GREEN
specialized cells that create the myelin sheath
grows into big sheets that wrap around the axon over and over; nucleus remains on the outside (little bump)
neurilemma — the sheet itself (Schwann cell membrane)

nucleus
LIGHT RED
contains the genetic information for a particular neuron

axon hillock
BROWN
impulses generate here once enough stimuli have been received by the dendrites
WOUND HEALING
the process by which an injury to a tissue or group of tissues is recognized, responded to, and healed
inflammatory response
generalized, non-specific way to minimize damage and prevent further injury
involves participation of mast cells & macrophages
immune response
antigen-specific attack against recognized invaders (germs, fungi, etc.)
involves participation of white blood cells (specifically lymphocytes), which produce antibodies against a specific threat
regeneration
the process by which damaged cells in injured tissue are replaced with new cells via mitotic cell divison
new tissue retains functionality
fibrosis
the process of using dense fibrous connective tissue in scar formation
new tissue is nonfunctional
chondrocytes
mature cells that “live” in lacunae and help maintain cartilage